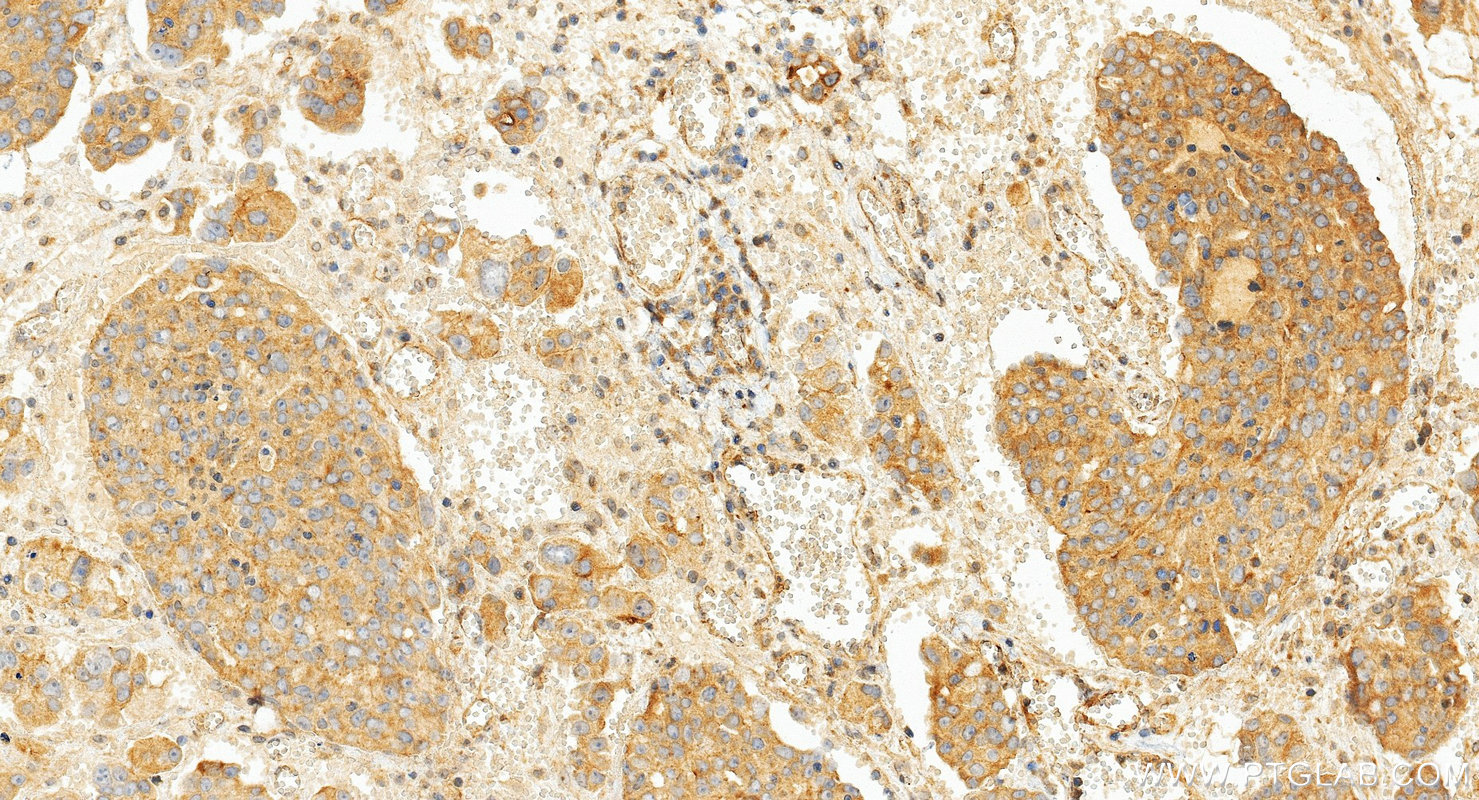
IHC staining of human ovary cancer using 17590-1-AP (same clone as 17590-1-PBS)

验证数据展示
产品信息
17590-1-PBS targets TNF-alpha in WB, IHC, IF/ICC, ELISA applications and shows reactivity with human, mouse samples.
| 经测试应用 | WB, IHC, IF/ICC, ELISA Application Description |
| 经测试反应性 | human, mouse |
| 免疫原 |
CatNo: Ag11433 Product name: Recombinant human TNF-a protein Source: e coli.-derived, PGEX-4T Tag: GST Domain: 1-233 aa of BC028148 Sequence: MSTESMIRDVELAEEALPKKTGGPQGSRRCLFLSLFSFLIVAGATTLFCLLHFGVIGPQREEFPRDLSLISPLAQAVRSSSRTPSDKPVAHVVANPQAEGQLQWLNRRANALLANGVELRDNQLVVPSEGLYLIYSQVLFKGQGCPSTHVLLTHTISRIAVSYQTKVNLLSAIKSPCQRETPEGAEAKPWYEPIYLGGVFQLEKGDRLSAEINRPDYLDFAESGQVYFGIIAL 种属同源性预测 |
| 宿主/亚型 | Rabbit / IgG |
| 抗体类别 | Polyclonal |
| 产品类型 | Antibody |
| 全称 | tumor necrosis factor (TNF superfamily, member 2) |
| 别名 | TNF, TNF alpha, TNF-a, C-domain 1, C-domain 2 |
| 计算分子量 | 233 aa, 26 kDa |
| 观测分子量 | 26 kDa |
| GenBank蛋白编号 | BC028148 |
| 基因名称 | TNF-alpha |
| Gene ID (NCBI) | 7124 |
| ENSEMBL Gene ID | ENSG00000232810 |
| RRID | AB_2271853 |
| 偶联类型 | Unconjugated |
| 形式 | Liquid |
| 纯化方式 | Antigen affinity purification |
| UNIPROT ID | P01375 |
| 储存缓冲液 | PBS only, pH 7.3. |
| 储存条件 | Store at -80°C. The product is shipped with ice packs. Upon receipt, store it immediately at -80°C |
背景介绍
TNF, as also known as TNF-alpha, or cachectin, is a multifunctional proinflammatory cytokine that belongs to the tumor necrosis factor (TNF) superfamily. It is expressed as a 26 kDa membrane bound protein and is then cleaved by TNF-alpha converting enzyme (TACE) to release the soluble 17 kDa monomer, which forms homotrimers in circulation. It is produced chiefly by activated macrophages, although it can be produced by many other cell types such as CD4+ lymphocytes, NK cells, neutrophils, mast cells, eosinophils, and neurons. It can bind to, and thus functions through its receptors TNFRSF1A/TNFR1 and TNFRSF1B/TNFBR. This cytokine is involved in the regulation of a wide spectrum of biological processes including cell proliferation, differentiation, apoptosis, lipid metabolism, and coagulation. This cytokine has been implicated in a variety of diseases, including autoimmune diseases, ins resistance, and cancer.